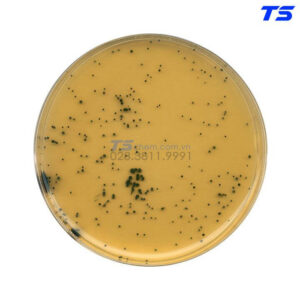

Lĩnh vực vi sinh vật đã có những bước phát triển vượt bậc trong vài thập kỷ gần đây. Nhiều loại vi khuẩn và vi sinh vật mang nhiều đặc tính khác nhau từ lành tính đến có hại được phát hiện nhờ vào quá trình nghiên cứu, phân tích trong phòng thí nghiệm.
Thông thường, mỗi loại vi khuẩn, vi sinh vật có môi trường tối ưu riêng vì vậy mà nhiều loại môi trường vi sinh ra đời nhằm nuôi cấy và duy trì sự sống của chúng để phục vụ cho việc nghiên cứu, ứng dụng sau này.
MÔI TRƯỜNG VI SINH LÀ GÌ?
Môi trường vi sinh là hỗn hợp các chất dinh dưỡng được tạo ra để nuôi cấy và duy trì sự sống của các vi sinh vật như vi khuẩn, nấm mốc và nhiều tác nhân vi sinh khác. Môi trường này được thiết kế đặc biệt để đảm bảo được điều kiện lý tưởng cho vi sinh vật phát triển và sinh trưởng như thành phần dinh dưỡng, điều kiện môi trường vật lý, sinh học,… Nhằm phục vụ cho quá trình nghiên cứu, phân tích và ứng dụng trong nhiều lĩnh vực từ Y học, Sinh học, Nông nghiệp đến Công nghiệp thực phẩm.


Môi trường nuôi cấy vi sinh đóng vai trò vô cùng quan trọng trong công tác nghiên cứu, xác định tính chất và khả năng sinh trưởng của sinh vật. Ngoài ra còn giúp phát hiện và xác định chính xác các loại vi sinh vật có trong từng mẫu vật được nghiên cứu.
CÁC LOẠI MÔI TRƯỜNG VI SINH TRONG NGHIÊN CỨU
Mỗi loại môi trường vi sinh sẽ có những chức năng khác nhau, thông thường để chọn được loại môi trường phù hợp cho việc nghiên cứu thí nghiệm, các chuyên gia thường dựa vào các yếu tố sau để lựa chọn:
Dựa vào thành phần môi trường
Môi trường nuôi cấy vi sinh tự nhiên: Môi trường này chứa nhiều chất hữu cơ, tuy nhiên không biết rõ thành phần hóa học nên còn được gọi là môi trường không xác định. Trong môi trường này thường chứa dịch chiết từ thịt bò hoặc các loại nấm men;
Môi trường nuôi cấy vi sinh tổng hợp: Ngược lại với môi trường vi sinh tự nhiên, đây được gọi là môi trường xác định bởi các thành phần hóa học bên trong đều được biết rõ. Môi trường này chứa các dung dịch hóa chất tinh khiết pha loãng, không chứa nấm men hay các mô động thực vật nên thường được dùng cho mục đích nghiên cứu.
Dựa vào trạng thái môi trường
Môi trường đặc: Nhóm môi trường này thường đông đặc lại bởi trong thành phần có bổ sung thêm thạch (Agar – Agar), Silicagel hay Gelatin;
Môi trường bán đặc: Cũng tương tự như môi trường đặc, trong thành phần môi trường đặc cũng chứa thạch, tuy nhiên chỉ chứa một lượng nhỏ từ từ 0,2 – 0,7%. Môi trường này được dùng để quan sát khả năng di chuyển của các vi sinh vật;
Môi trường lỏng: Môi trường này không chứa các chất làm đặc, nhóm môi trường nuôi cấy vi sinh này thường được dùng trong nghiên cứu và cả trong sản xuất tại các nhà máy công nghiệp.
Dựa vào mục đích dùng
Môi trường vi sinh cơ bản: Đây là môi trường cung cấp các điều kiện cơ bản như nhiệt độ, độ pH, các chất dinh dưỡng cần thiết như nguồn Carbon, năng lượng, muối, Axit Amin và Vitamin để vi sinh vật sống và phát triển;
Môi trường kỵ khí: Môi trường này được tạo ra để hạn chế hoặc loại trừ sự hiện diện của oxy, nhằm tạo điều kiện cho sự phát triển của nhóm vi sinh vật không cần oxy hoặc cần lượng oxy rất thấp;
Môi trường vận chuyển: Nhóm môi trường này được sử dụng nhằm để bảo quản và vận chuyển vi sinh vật từ một nơi đến nơi khác mà vẫn đảm bảo được sự sống và hoạt động của chúng. Đảm bảo được số lượng vi sinh vật trong mẫu;
Môi trường tăng sinh: Chứa các chất dinh dưỡng tối ưu, nhằm để hỗ trợ cho sự phát triển, tăng trưởng và sinh sản của vi sinh vật cũng như các tác nhân hóa học và vật lý khác để tăng số lượng vi sinh vật;
Môi trường chọn lọc: Môi trường này được điều chỉnh đặc biệt để tạo điều kiện thuận lợi cho sự sống và phát triển của một nhóm vi sinh vật cụ thể, trong khi tất cả những vi sinh vật khác sẽ bị kháng lại;
Môi trường biệt hóa: Đây là môi trường được sử dụng để phân lập và nuôi cấy một loại vi sinh vật cụ thể trong một mẫu có chứa nhiều loại vi sinh vật khác nhau;
Môi trường chọn lọc/biệt hóa: Môi trường này đều có đặc tính của môi trường chọn lọc và biệt hóa, chúng được sử dụng để cung cấp điều kiện tối ưu cho một loại vi sinh vật cụ thể trong khi các vi sinh vật khác đều bị ngăn chặn lại;
Môi trường phân tích: Đây là môi trường được sử dụng để phân tích và xác định các đặc điểm sinh hóa, hóa học hoặc vật lý của vi sinh vật, nhằm nghiên cứu và đánh giá các tính chất của chúng.
ỨNG DỤNG CỦA MÔI TRƯỜNG NUÔI CẤY VI SINH


Có thể thấy môi trường vi sinh vô cùng đa dạng vì vậy mà nhóm hóa chất này cũng được ứng dụng trong nhiều lĩnh vực như:
Y tế: Trong y học để chẩn đoán chính xác và điều trị các bệnh liên quan đến vi sinh vật, các vi khuẩn, nấm và vi rút được nuôi cấy và phân tích để xác định được loại vi sinh vật gây bệnh từ đó đưa ra phương pháp điều trị phù hợp. Ngoài ra, môi trường nuôi cấy vi sinh được sử dụng để sản xuất các loại Vacxin và thuốc kháng sinh ngày nay;
Quản lý môi trường: Trong quản lý và xử lý chất thải, môi trường vi sinh đóng vai trò rất quan trọng. Vi sinh vật được nuôi cấy trong môi trường thích hợp sẽ có khả năng phân giải các chất hữu cơ trong nước, đất và chất thải công nghiệp từ đó đưa ra các giải pháp làm giảm ô nhiễm môi trường và bảo vệ sức khỏe con người;
Công nghiệp thực phẩm: Môi trường này được sử dụng trong sản xuất thực phẩm để kiểm tra sự hiện diện của vi khuẩn gây bệnh trong thực phẩm, từ đó đảm bảo chất lượng an toàn cho thực phẩm và đáp ứng các tiêu chuẩn vệ sinh;
Nông nghiệp: Môi trường vi sinh giúp cải thiện sự sinh trưởng và năng suất cây trồng. Vi sinh vật được nuôi cấy có thể sử dụng để tạo ra phân bón hữu cơ, ổn định đất và giảm sự cạnh tranh giữa các loại vi sinh vật có lợi và có hại;
Công nghệ sinh học: Các vi sinh vật nuôi cấy trong môi trường nuôi cấy vi sinh có thể được sử dụng để sản xuất các sản phẩm sinh học như Enzym, Protein và Axit Amin cũng như sản xuất nhiên liệu sinh học và các sản phẩm tái sinh khác.
BẢNG GIÁ MÔI TRƯỜNG VI SINH MỚI NHẤT TẠI TSCHEM
| Thương hiệu | Tên sản phẩm | Quy cách | Giá dự kiến (VNĐ) |
| Himedia | Môi trường vi sinh Plate count agar – M091 | Chai nhựa 500G | 1.000.000 – 1.100.000 |
| Himedia | Môi Trường Soybean Casein Digest Medium (Tryptone Soya Broth) – M011 | Chai nhựa 500G | 520.000 – 650.000 |
| Himedia | Hóa chất TCBS Agar (Selective) – M870 | Chai nhựa 500G | 1.180.000 – 1.250.000 |
| Himedia | Hóa chất Violet Red Bile Agar – M049 | Chai nhựa 500G | 1.100.000 – 1.250.000 |
| Himedia | Hóa chất Buffer Peptone Water – M614 | Chai nhựa 500G | 900.000 – 950.000 |
| Merck | Môi trường vi sinh Plate Count Agar – 105463 | Chai nhựa 500G | 1.800.000 – 1.950.000 |
| Merck | Môi trường vi sinh VRBD agar – 101406 | Chai nhựa 500G | 1.560.000 – 1.650.000 |
| Merck | Môi trường vi sinh Trypticase Soy Agar – 105458 | Chai nhựa 500G | 1.950.000 – 2.100.000 |
| Merck | Hóa chất Peptone water – 107228 | Chai nhựa 500G | 1.275.000 – 1.300.000 |
| Merck | Môi trường vi sinh BGBL Brila broth – 105454 | Chai nhựa 500G | 2.730.000 – 2.800.000 |
Bảng giá cập nhật T6/2023 chỉ mang tính chất tham khảo, có thể thay đổi phù hợp với từng giai đoạn. Đối với những sản phẩm không có trong bảng giá này Quý Khách hàng vui lòng liên hệ Trung Sơn để được báo giá chi tiết.
TRUNG SƠN – NƠI CUNG CẤP MÔI TRƯỜNG NUÔI CẤY VI SINH UY TÍN
Ngoài việc lựa chọn loại môi trường vi sinh phù hợp với mục đích sử dụng các Nhà nghiên cứu, các Tổ chức y tế và các Công ty trong ngành công nghiệp cần phải chú trọng đến chất lượng và độ tinh khiết của môi trường để đảm bảo kết quả nghiên cứu và ứng dụng chính xác và đáng tin cậy.
Trung Sơn là Nhà cung cấp hàng đầu các loại môi trường vi sinh với hơn 200 sản phẩm nhập khẩu chính hãng 100%, đảm bảo chất lượng và độ tinh khiết cao. Chúng tôi cung cấp một loạt các loại môi trường nuôi cấy vi sinh đa dạng thương hiệu như Himedia, Merck. Hãy đến với Trung Sơn để được tư vấn và đáp ứng mọi nhu cầu về môi trường vi sinh của bạn.